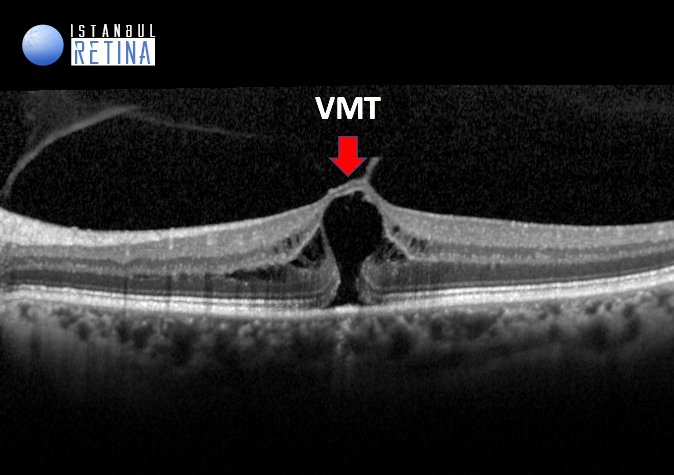

AMD
AMD Age-related Macular Degeneration
AMD is a progressive eye disease that damages the macula (the central part of the
retina), leading to loss of central vision. It primarily affects people over 50 years old and
is a leading cause of blindness in older adults
-
Types of AMD
1. Dry AMD (Atrophic)
o Most common (90% of cases).
o Caused by thinning of the macula and accumulation of drusen (yellow
deposits).
o Progresses slowly over years.
2. Wet AMD (Neovascular/Exudative)
o Less common but more severe.
o Caused by abnormal blood vessel growth under the retina, leading to
leakage & scarring.
Can cause rapid vision loss if untreated.
-
Symptoms of AMD
Blurred or distorted central vision (e.g., straight lines appear wavy).
Dark or empty spots in the center of vision.
Difficulty reading, recognizing faces, or seeing fine details.
Colors appear less bright.
Poor vision in low light.
Self-test: Use an Amsler Grid to check for vision distortions.
Causes & Risk Factors
• Aging (most common in people >50).
• Smoking (increases risk 3-4 times).
• Family history (genetics play a role).
• Cardiovascular diseases (high blood pressure, cholesterol).
• Treatment Options
1. Dry AMD
• No cure, but progression can be slowed with:
o AREDS2 supplements (Vitamin C, E, Zinc, Copper, Lutein, Zeaxanthin).
o Healthy diet (leafy greens, fish, nuts).
o Smoking cessation.
o Regular eye check-ups.
2. Wet AMD
• Anti-VEGF injections (Lucentis, Eylea, Avastin) to block abnormal blood vessels.
• Laser therapy (in some cases).
• Low-vision aids (magnifiers, screen readers).




CNV
CNV Choroidal Neovascularization
Choroidal Neovascularization (CNV) is the abnormal growth of blood vessels from
the choroid (a vascular layer beneath the retina) into the retina or subretinal space.
These vessels are fragile and leak fluid or blood, causing rapid vision loss if untreated.
Symptoms of CNV
Sudden or progressive vision problems, including:
✔ Blurred or distorted central vision (metamorphopsia).
✔ Dark spot (scotoma) in the center of vision.
✔ Straight lines appearing wavy (test with Amsler Grid).
✔ Flashes or floaters (if bleeding occurs).
Causes & Risk Factors
• Wet Age-Related Macular Degeneration (Wet AMD) – The most common cause.
• High Myopia (Pathologic Myopia).
• Inflammatory Eye Diseases (e.g., Uveitis).
• Eye Injuries or Infections (e.g., Ocular Histoplasmosis).
• Genetic Disorders (e.g., Pseudoxanthoma Elasticum).
Diagnosis
- Optical Coherence Tomography (OCT): Detects fluid or blood under the retina.
- Fluorescein Angiography (FA): Highlights leaking blood vessels.
- Indocyanine Green Angiography (ICGA): Helps identify deeper abnormal blood vessels, especially in cases of polypoidal choroidal vasculopathy (PCV).



CSR
CSR Central Serous Retinopathy
A condition where fluid accumulates under the retina (usually in the macular area),
causing partial retinal detachment and vision impairment. It most commonly
affects men aged 30-50, particularly those under stress or psychological pressure
Symptoms of CSR
✔ Blurred central vision (hazy spot in the central visual field).
✔ Dull color perception.
✔ Image appears smaller (micropsia).
✔ Dark spot in the center of vision.
✔ Distorted or tilted lines (visible when using an Amsler grid).
Causes & Risk Factors
• Stress and psychological pressure (primary cause).
• Corticosteroid use (oral, topical, or injectable).
• Pregnancy (due to hormonal changes).
• Sleep apnea.
• Family history.
Diagnosis
1. Fundus examination: Shows retinal swelling.
2. Optical Coherence Tomography (OCT): Detects fluid under the retina.
3. Fluorescein Angiography (FA): Reveals choroidal leakage.



DME
DME Diabetic Macular Edema
Diabetic Macular Edema is a complication of diabetic retinopathy where fluid leaks into
the macula (the central part of the retina), causing swelling and vision loss. It's a leading
cause of blindness in diabetic patients.
Symptoms of DME
✔ Blurred or distorted central vision
✔ Difficulty reading or recognizing faces
✔ Colors appearing washed out
✔ Floaters or dark spots
✔ Vision that changes day-to-day
Causes & Risk Factors
• Prolonged high blood sugar levels
• Long duration of diabetes (usually 10+ years)
• High blood pressure
• High cholesterol
• Pregnancy (can accelerate retinopathy)
Diagnosis
1. Dilated eye exam: Doctor checks for retinal changes
2. Optical Coherence Tomography (OCT): Shows retinal thickness and fluid
3. Fluorescein Angiography: Identifies leaking blood vessels
4. Visual acuity test: Measures vision sharpness




DR
DR Diabetic Retinopathy
A damage to the blood vessels in the retina caused by prolonged high blood sugar
levels. It's one of the leading causes of vision loss among adults worldwide.
Symptoms of DR
Early Stages (may be asymptomatic):
✔ Dark spots or floating strings (floaters)
✔ Blurred vision
✔ Difficulty seeing at night
Late Stages:
✔ Sudden vision loss
✔ Dark areas in visual field
✔ Faded colors
Causes & Risk Factors
Duration of diabetes (longer duration = higher risk)
Poor blood sugar control
High blood pressure
High cholesterol
Pregnancy
Smoking
Kidney disease
Obesity
Diagnosis
1. Dilated eye exam
2. Optical Coherence Tomography (OCT)
3. Fluorescein angiography
4. Visual acuity test
Treatment Options
Early Stages:
Improve blood sugar control
Manage blood pressure and cholesterol
Regular ophthalmologist follow-ups




DRUSEN
DRUSEN Yellow Deposits Under The Retina
Drusen are small yellow deposits that form under the retina, composed of
accumulated lipids and proteins. They represent an early sign of age-related retinal
changes and may indicate risk for macular degeneration.
Symptoms of DRUSEN
Often asymptomatic in early stages
May cause with progression: Mild blurred vision
Difficulty adapting to low light
Changes in color perception
Distorted or wavy vision (metamorphopsia)
Increased sensitivity to glare
Dark or blurry spots in central vision (scotomas)
Gradual central vision loss (if associated with age-related macular degeneration – AMD)
Causes & Risk Factors
Aging (most common after age 50)
Genetic predisposition
Smoking
Cardiovascular disease
Excessive UV exposure
Cardiovascular disease
Diagnosis
1. Dilated eye exam
2. Optical Coherence Tomography (OCT)
3. Retinal imaging
Treatment & Management
Regular monitoring (if small and asymptomatic)
Lifestyle modifications:
• Smoking cessation
• Leafy greens and fish in diet



MH
MH Macular Hole
A macular hole is a small break or defect in the macula, the central part of the retina
responsible for sharp, detailed vision. It typically develops gradually and can significantly
impair central vision while leaving peripheral vision intact.
Symptoms of MH
Central vision blurring or distortion
Straight lines appearing wavy (Amsler grid test)
Dark spot in central vision
Difficulty reading small print
Colors appearing washed out
Causes & Risk Factors
Age-related vitreous shrinkage (most common in ages 60-80)
Eye trauma (blunt injury)
High myopia (severe nearsightedness)
Diabetic eye disease
Retinal inflammation
Diagnosis
1. Comprehensive eye exam
2. Optical Coherence Tomography (OCT) – Gold standard
3. Amsler grid testing
4. Fluorescein angiography (to rule out other conditions)